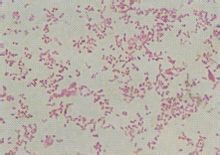
嗜血桿菌

簡介
嗜血桿菌
血清群
嗜血桿菌分類為兩類,即 莢膜菌株及 沒有莢膜的菌株。已知莢膜類的乙型流感嗜血桿菌(或是b型流感嗜血桿菌,簡稱HiB)是毒性的主因之一,但感染嗜血桿菌的病因卻仍未完全清楚。它們的莢膜能幫助它們抵抗在沒有免疫的寄主體內的吞噬作用及不觸發補體介導的裂解。
沒有莢膜的菌株則較少侵略性,但它們能誘發炎症而產生其他病症,如會厭炎。
病症
大部份嗜血桿菌都是機會性感染 細菌,即它們會在寄主體內生存而不引起任何疾病,但當某一些因素(如 病毒感染或 免疫力下降)出現後則會引發病症。 嗜血桿菌一般有六種菌株,稱為a型、b型(又稱乙型)、c型、d型、e型及f型。由嗜血桿菌自然產生的疾病只會在人類出現。在嬰兒及孩童中,乙型流感嗜血桿菌會引致菌血病症及急性細菌性腦膜炎。偶而地它會引致蜂窩組織炎、骨髓炎及關節感染。自從1990年開始,美國使用HiB結合型疫苗後,HiB病症的患病率減少至每十萬名兒童有1.3名兒童感染。但是,HiB仍然是開發中國家引致嬰兒及兒童下呼吸道疾病的主因。沒有莢膜的流感嗜血桿菌會引致兒童的耳朵感染(如中耳炎)、眼睛感染(結膜炎)及鼻竇炎,並且聯帶肺炎。
與肺炎鏈球菌的相互關係
 嗜血桿菌
嗜血桿菌 嗜血桿菌與肺炎鏈球菌都能在人類的上呼吸系統中發現。一項有關它們之間的競爭研究指出,在培養基內,肺炎鏈球菌能以過氧化氫攻擊流感嗜血桿菌及能排除在表面流感嗜血桿菌生存所需的分子。
當兩種細菌一同在鼻腔內時,兩星期之內,只有流感嗜血桿菌能夠生存。當兩種細菌分別地放在鼻腔內時,兩者皆能生存。使實驗鼠的上呼吸組織暴露於兩種細菌時,發現有格外大量的中性粒細胞。當實驗鼠只是暴露於其中一種細菌時,則不會出現這些細胞。
實驗顯示,接觸過嗜血桿菌死菌的中性粒細胞對肺炎鏈球菌會強烈攻擊,而未接觸過流感嗜血桿菌死菌的中性粒細胞的這種攻擊則較不會這么強烈。接觸流感嗜血桿菌死菌,卻不會對流感嗜血桿菌活菌有所影響。這種現象有兩種可能性:
當嗜血桿菌被肺炎鏈球菌攻擊時,引發了免疫系統攻擊肺炎鏈球菌。
兩種細菌的結合引發了只有其中一種細菌存在所不會引發的免疫系統警報。
至於為何流感嗜血桿菌會不受免疫系統的影響則不得而知。
預防和治療
預防
 嗜血桿菌
嗜血桿菌 接種HiB結合型疫苗是一種有效的預防方法,其中某幾種疫苗已經廣為使用。
除預防以外,治療主要是病因治療。該菌對磺胺、青黴素、鏈黴素、四環素、氨苄青黴素和氯黴素均敏感,對b型莢膜流感桿菌的急性感染,尤其是腦膜炎、會厭炎,過去均以氨苄青黴素為首選,有的國家報告耐氨苄青黴素的菌株逐年增加,故有人以氯黴素為首選。
提倡用b型流感嗜血桿菌聯合疫苗於嬰兒2、4和6個月時分3次注射。
治療
體重在20kg以下兒童每天按100mg/kg靜脈注射氨苄青黴素,20kg以上兒童和成年人用量為250mg~1g,每6小時1次。
另一種辦法是口服羥氨苄青黴素,20kg以下兒童20~40mg/kg,每日3次;20kg以上兒童和成年人250~500mg,每日3次;約30%的流感嗜血桿菌產生β-內醯胺酶且對氨苄西林耐藥。因此,常用的治療方案為:磺胺甲基異囉唑/甲氧苄氨嘧啶(SMX/TMP)兒童每日8mg/40mg/kg,口服或靜脈注射,成人則為口服1~2片(每片為160mg/800mg),每日2次;頭孢呋辛0.25~1g靜脈注射,每6小時1次;頭孢克羅兒童每日20~40mg/kg,分3次口服,成人500mg口服,每6小時1次;或強力黴素100mg口服,每日2次(8歲以下兒童忌用)。
對非耐藥菌株,在小於20kg兒童可予氨苄青黴素每日100mg/kg,分4次靜脈注射(最大劑量為每日2~3g),在大於20kg兒童及成人則為250mg~1g,每6小時1次靜脈注射。
尚可使用阿莫西林,對小於20kg兒童,可予20~40mg/kg口服,每日3次;對大於20kg兒童及成人,可予250~500mg,每日3次。氟喹諾酮和阿奇黴素對流感嗜血桿菌亦有抗菌活性。
定序
因嗜血桿菌的基因體稀少,嗜血桿菌是第一種排列全數基因體,而又能自由生存的生物。它的基因體包含了1,830,140的DNA鹼基對及1740個基因。嗜血桿菌的基因排序計畫由基因組研究所策劃,於1995年完成及刊登於《科學》雜誌上。

